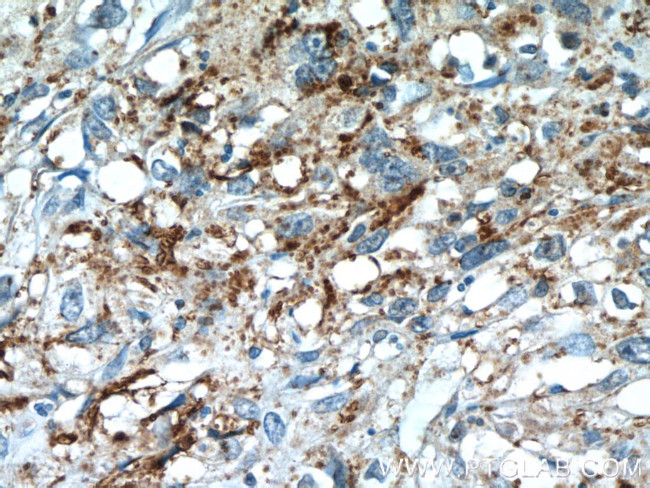
PIWIL2 Antibody in Immunohistochemistry (Paraffin) (IHC (P))

Search
Proteintech
PIWIL2 Polyclonal Antibody
{{$productOrderCtrl.translations['antibody.pdp.commerceCard.promotion.promotions']}}
{{$productOrderCtrl.translations['antibody.pdp.commerceCard.promotion.viewpromo']}}
{{$productOrderCtrl.translations['antibody.pdp.commerceCard.promotion.promocode']}}: {{promo.promoCode}} {{promo.promoTitle}} {{promo.promoDescription}}. {{$productOrderCtrl.translations['antibody.pdp.commerceCard.promotion.learnmore']}}
产品信息
14209-1-AP
种属反应
宿主/亚型
分类
类型
抗原
偶联物
形式
浓度
规格
纯化类型
保存液
内含物
保存条件
运输条件
产品详细信息
Immunogen sequence: AEGKIQMVV CIIMGPRDDL YGAIKKLCCV QSPVPSQVVN VRTIGQPTRL RSVAQKILLQ INCKLGGELW GVDIPLKQLM VIGMDVYHDP SRGMRSVVGF VASINLTLTK WYSRVVFQMP HQEIVDSLKL CLVGSLKKFY EVNHCLPEKI VVYRDGVSDG QLKTVANYEI PQLQKCFEAF ENYQPKMVVF VVQKKISTNL YLAAPQNFVT PTPGTVVDHT ITSCEWVDFY LLAHHVRQGC GIPTHYVCVL NTANLSPDHM QRLTFKLCHM YWNWPGTIRV PAPCKYAHKL AFLSGHILHH EPAIQLCENL FFL (662-973 aa encoded by BC025995)
靶标信息
The piwi gene of Drosophila belongs to a novel class of evolutionarily conserved genes (the piwi or Argonaute family). The Piwi family is required for germ and stem cell development in invertebrates, and two Piwi members, MIWI and MILI (Miwi like, Piwil2, Piwi-like protein 2), are essential for spermatogenesis in mouse. MIWI and MILI partner with Piwi-interacting RNAs (piRNAs) which are 26-31 nucleotides in length clearly distinct from the 21-23 nucleotides of microRNAs (miRNAs) or short interfering RNAs (siRNAs). A search for murine small RNAs that might program Piwi proteins for transposon suppression revealed developmentally regulated piRNA loci, some of which resemble transposon master control loci of Drosophila. MILI might be programmed by distinct piRNA populations at different stages of germ cell development, suggesting MILI plays an important role in meiotic prophase progression.
仅用于科研。不用于诊断过程。未经明确授权不得转售。
生物信息学
蛋白别名: Cancer/testis antigen 80; CT80; Miwi like; Miwi likw; piwi like homolog 2; PIWI-L2; piwi-like 2; piwi-like homolog 2; Piwi-like protein 2; PIWIL2; piwil2-like protein; PL2L106; PL2L80A; testicular tissue protein Li 141; unnamed protein product
基因别名: CT80; HILI; Mili; PIWIL1L; PIWIL2
UniProt ID: (Human) Q8TC59, (Mouse) Q8CDG1
Entrez Gene ID: (Human) 55124, (Rat) 306011, (Mouse) 57746